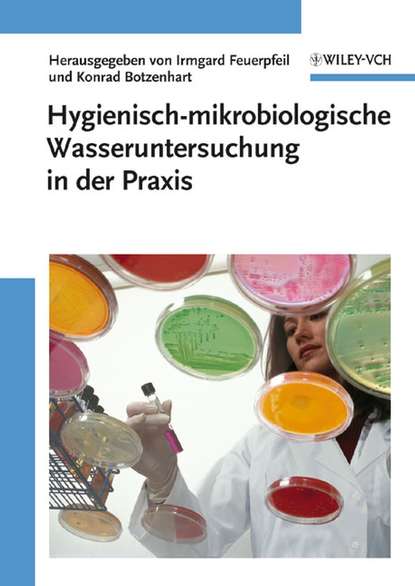
Скачать книгу Hygienisch-mikrobiologische Wasseruntersuchung in der Praxis

Поиск:
Войти
Полная версия
Alle gangigen mikrobiologischen Nachweismethoden sind hier fur den Praktiker zusammengestellt. Sie werden mit Hilfe von Flu?diagrammen und Referenzergebnissen leicht nachvollziehbar erklart. Zu jedem Nachweis werden die gesetzlichen Anforderungen und Bewertungsma?stabe erlautert – sowohl auf nationaler wie auf EU-Ebene. Damit ist das Werk eine sinnvolle Erganzung der DEV-Loseblattsammlung. Unverzichtbar fur alle, die Wasseruntersuchungen in Auftrag geben, durchfuhren oder bewerten wollen.
- О книге
- Читать
Читать онлайн «Hygienisch-mikrobiologische Wasseruntersuchung in der Praxis»
Отзывы о книге «Hygienisch-mikrobiologische Wasseruntersuchung in der Praxis»
Другие книги автора:
Популярные книги